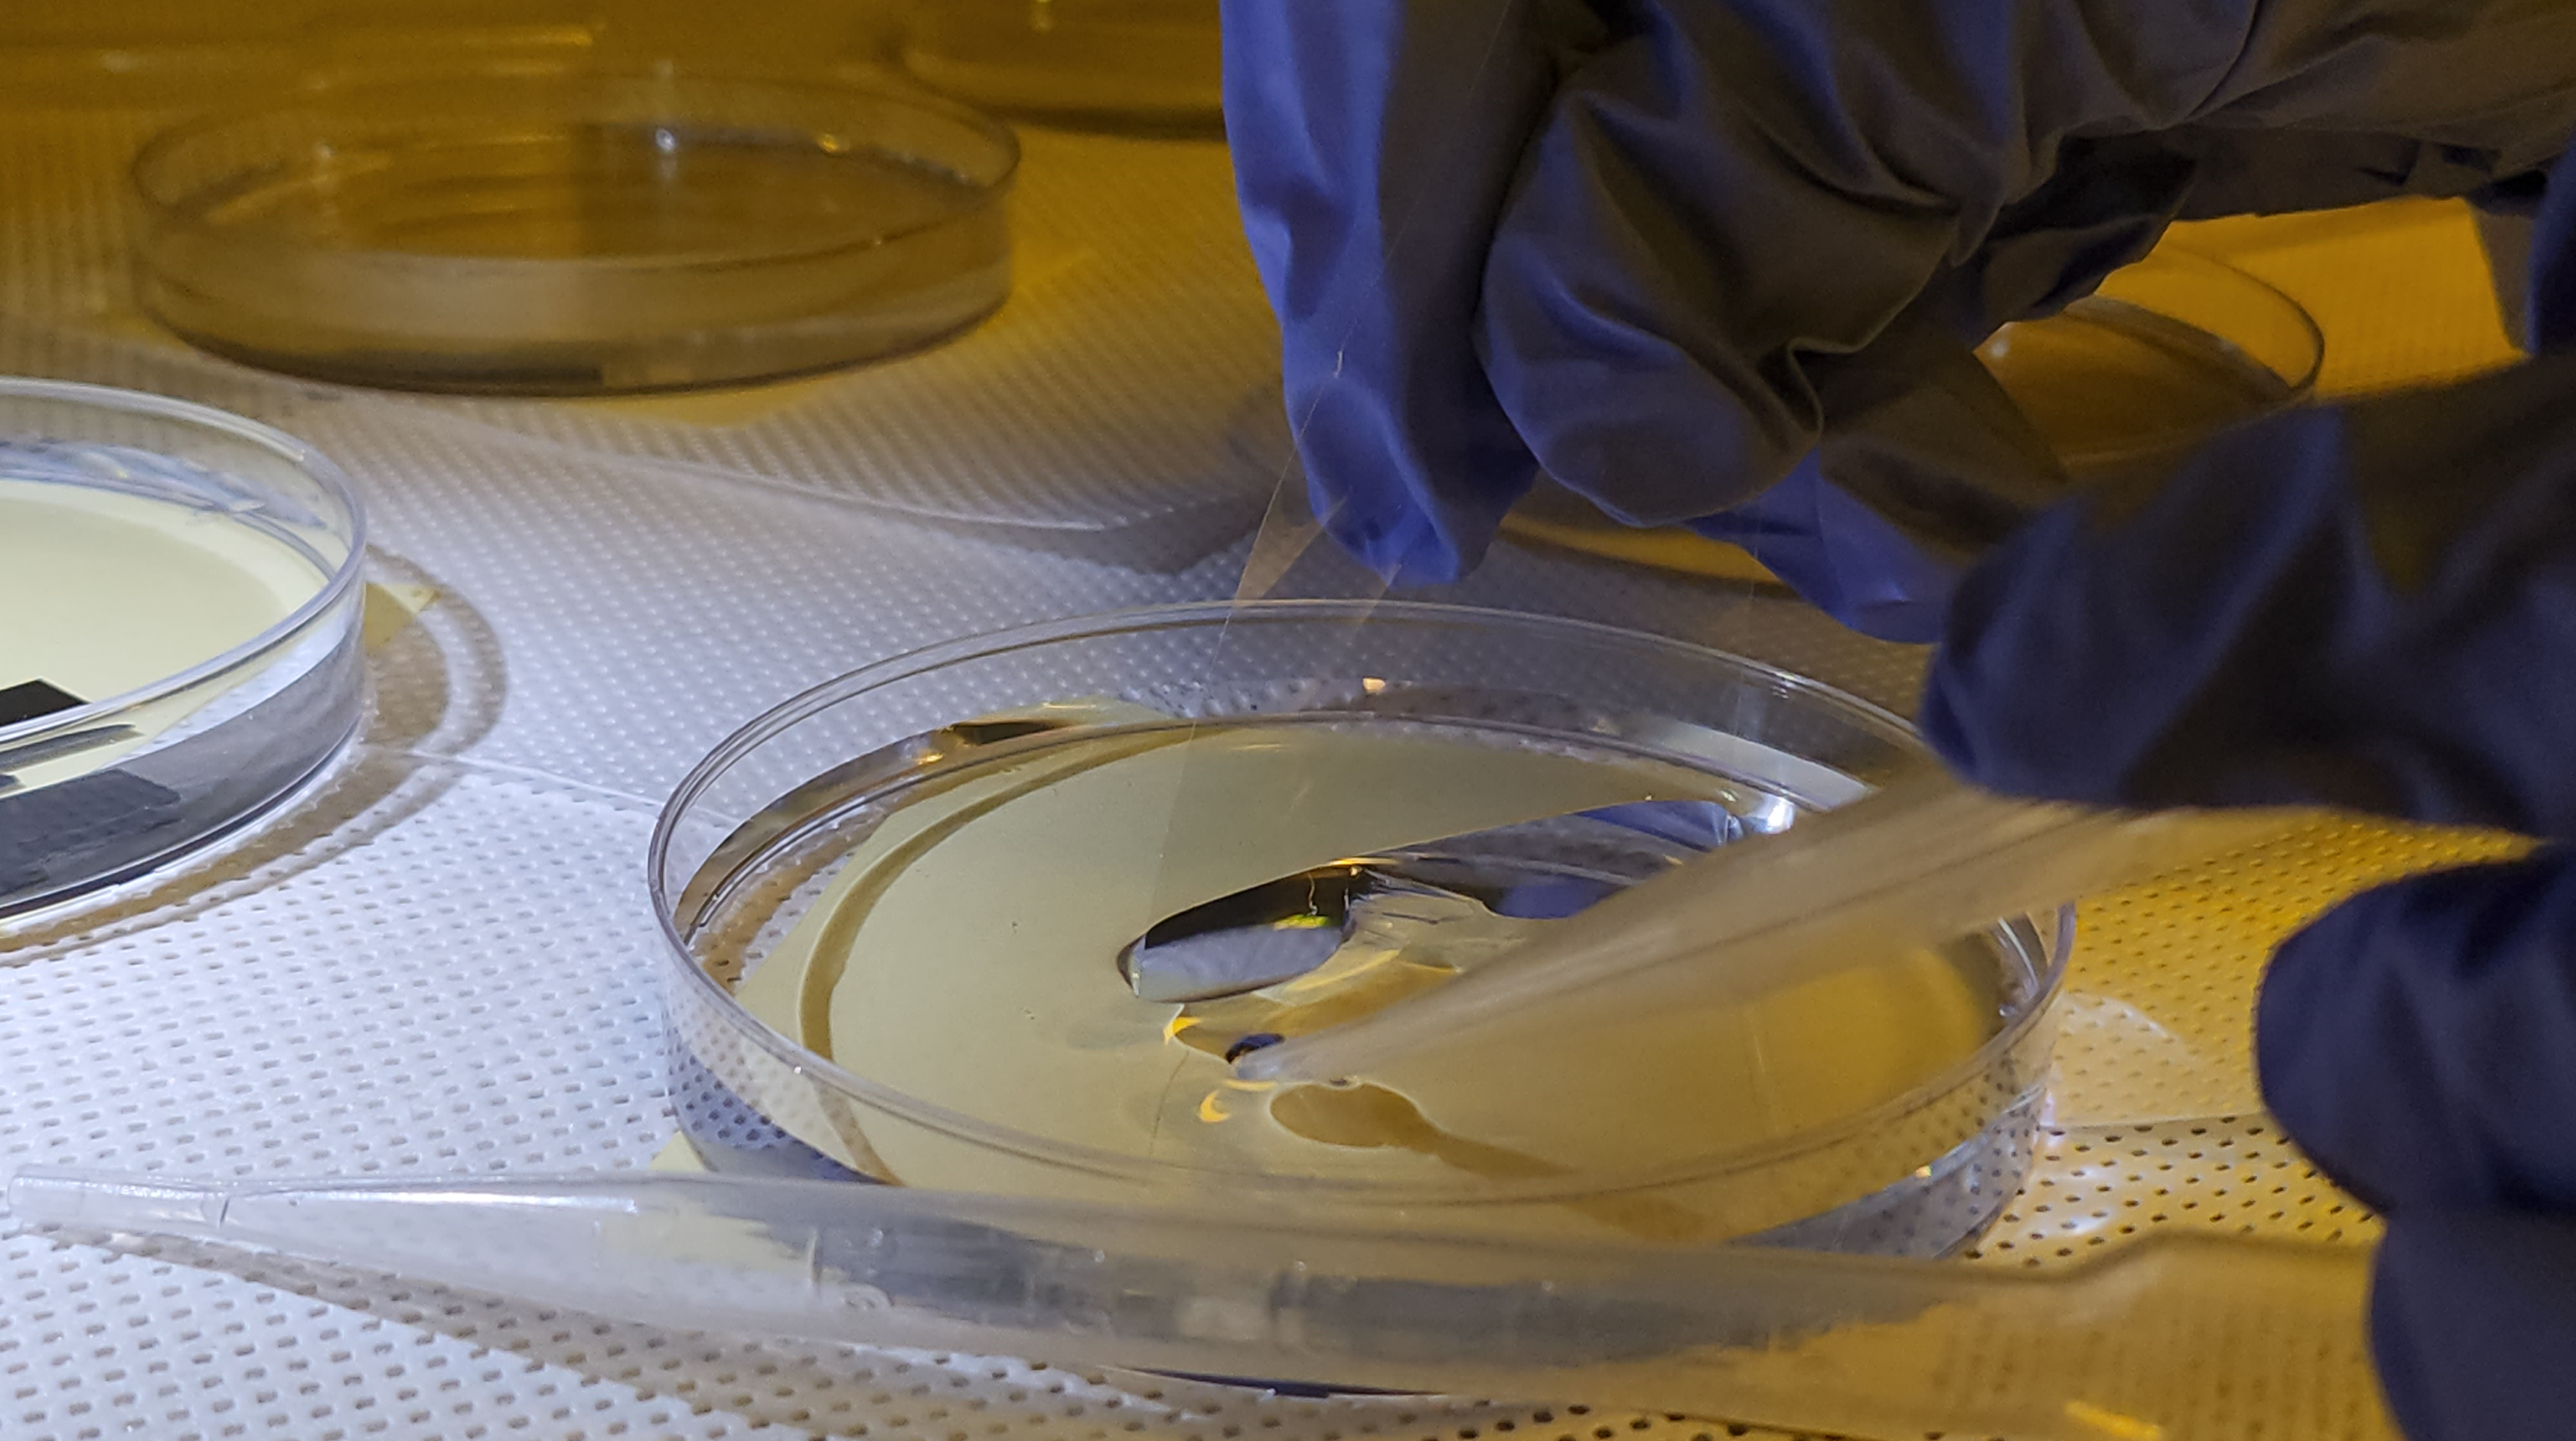

CNT Growth

1. Precursor Recipe - [N센터 5층 86591]

- 공정실에서 Wafer desiccator 안에 있는 [PVP], [Al2O3], [Molyb], [Fe3] 꺼내기.
- 피펫 넉넉하게 7개 챙기기.
| No. | Material | [ milli gram ] | [ At gram ] |
|---|---|---|---|
| 01 | IPA | - | 1.5 [g] |
| 02 | DI Water | 15 [ml] | 15 [g] |
| 03 | PVP | 15 [mg] | 0.015 [g] |
| 04 | Al2O3 Nanoparticles | 15 [mg] | 0.015 [g] |
| 05 | MoO3 Bis Dioxo Molybdenum (VI) | 2 [mg] | 0.002 [g] |
| 06 | Fe(No3)3 9H2O | 20 [mg] | 0.02 [g] |
- Recipe 순서대로 배합하기.
i) Al2O3가 종이에 너무 잘 붙으므로 여분 조금 더 넣기.
ii) Fe3는 습기에 약하므로 뚜껑 꼭 닫기. - Sonic의 물 온도가 40°C 넘지 않도록 하면서 1시간 Wave치기.

- Color : Light Orange(밝은 오렌지 색)
- 완성된 Precursor는 밝은 오렌지 색 + 맑은 느낌임.

- 남은 IPA는 Organic에 버리기.
[Coution]
- FeNo3 가 수분에 취약하므로 잘 보관
- Precursor 제작 후, 1~2주가 지나면 CNT Quality 감소
- IPA 먼저 Volume 측정, DI water 넣어서 섞은 후, FeNo3를 마지막에 넣는다
- Mixing in Sonicator in 1 hours (Change water every 30 minutes Because Heat)
- Before growth, sonicate in 15 minutes
- When Deeping the Catalyst, Deeping edge of substrate in solution
- Put it in a heater 110°C for 10 min
2. Wafer Slice

- Wafer를 사용하기 편하게 1.2 x 1.2 [cm]로 Slice함.
3. Wafer Cleaning



[Acetone & IPA]
- Acetone과 IPA(Isoproyl Alcohol)을 사용하여 Wafer에 남아있는 Particle 제거 및 Cleaning
- Acetone : Using Acetone to remove organic contaminants
- IPA : Using Isopropyl Alcohol(IPA) to remove residual Acetone and other contaminants
- Acetone과 IPA를 비커에 담기.
- Wafer 거치대에 Die를 Load하고, Acetone에 담궈서 Sonic 5분 Wave치기.
- Sonic 끝난 Wafer를 IPA에 씻은 후, N2 Gas로 Drying 하기.
4. O2 RIE - [제1공학관 23415]

[Reactive Ion Etching]
- RIE를 통해 Acetone과 IPA로 Clean해도 남아있을 수 있는 잔여 Particle을 제거
- Wafer에 1 [min] 동안 Ozone Plasma 처리를 하여, 기존 Hydrophobic(소수성)의 Wafer 표면을 Hydrophilic(친수성)으로 변화
[Definition]
• Reactive Ion Etching (RIE) – Physical + Chemical / Ion + Radical
• Sputter Etching – Physical Etch / Using Ion
• Plasma Etching – Chemical Etch / Using Radical
[Process]
- Plasma Chamber 내부에 Gas 주입
- Energe 인가에 따른 전자 가속화
- Plasma 생성에 따른 Radical + Ion+ 생성
- Etchant 물질이 확산에 의해 Target 표면으로 이동 및 흡착
- Ion Bombardment에 의해 약해진 영역에서 Etchant 물질과 반응하여 휘발성 화합물 생성
- 화합물 표면 탈착
- 확산에 의한 배출
- o2_cnt Recipe로 Wafer를 O2 Gas로 1 [min]동안 RIE 치기.
5. Precursor Spin Coating

[RPM & Time]
Program Number : 29
1. 500 [RPM], 5 [sec] : 도포
2. 1350 [RPM], 60 [sec] : 균일화
[Bake Temp & Time]
180°C & 1 [Min]
- 위에 있는 Recipe No.29로 Precursor를 Spin Coating 하기.
- 180°C Hot Plate에서 1 [min]동안 Soft Bake하기.
6. CNT Growth Schematic


- CVD Chamber에서 Process에 맞게 CNT Growing 시키기.
[Schematic]



[A | 00:00 ~ 00:05 | 0°C]
Ar : 1000 [SCCM]
CVD Chamber 안정화[B | 00:05 ~ 00:25 | 0~900°C]
H2 : 500 [SCCM]
Ar : 100 [SCCM]
CVD Chamber 안정화 + 900°C까지 가열[C | 00:25 ~ 00:30 | 900°C]
CH4 : 500 [SCCM]
H2 : 500 [SCCM]
CNT 성장[D | 00:30 ~ 02:00 | 900~0°C]
H2 : 500 [SCCM]
Ar : 100 [SCCM]
CVD Chamber Cooling

- Cooling 시킨 후, 꺼내기.
7. PMMA Coating


[PMMA Coating]
- HF가 CNT에 Damage를 주는 것을 막기 위해 CNT 위에 PMMA를 코팅함.
- Flim 형태로 Transfer 하기 쉽게 하기 위해 CNT 위에 PMMA를 코팅함.
[RPM & Time]
Program Number : 19
1. 500 [RPM], 5 [sec] : 도포
2. 3550 [RPM], 60 [sec] : 균일화
[Bake Temp & Time]
180°C & 1 [Min]
- Recipe No.19로 PMMA를 Spin Coating 하기.
- 180°C Hot Plate에서 1 [min]동안 Soft Bake하기.
8. E-Beam Marked Wafer Slice


[E-Beam Maker]
OM, SEM 등으로 Sample을 확인하였을 때, 어느 위치를 확인하고 있는지 알기 위해 Wafer 바탕에 E-Beam으로 숫자 등의 표식을 Photo함.
- E-Beam Marked Wafer를 사용하기 편하게 1.2 x 1.2 [cm]로 Slice함.
9. Scratching CNT Edge



[PMMA Coating]
Spin Coating된 PMMA가 Sample 겉에도 도포될 가능성이 있음.
따라서 [PMMA | CNT | SiO2] 층을 긁어서 제거하여 Lift Off를 위한 HF가 침투할 수 있도록 함.
- 면도날로 Sample의 겉을 긁어서 단차 만들어주기.
10. CNT Transfer


[HF]
HF는 산화된 실리콘(SiO2)을 녹일 수 있음.
따라서 희석된 HF 용액에 Sample을 집어넣고 주위에 해당 용액을 떨어뜨려 파형을 만들어 줌.
해당 과정에서 HF가 SiO2를 녹이게 됨.
결국 PMMA에 CNT가 붙어있는 상태로 Lift Off 될 수 있음.
- Petri Dish 6개, Pipette 6개, OHP Flim 2개를 Fume Hood에 준비함.
- Petri Dish 1개에 HF와 DI Water를 희석하여 준비함.
- 나머지 Petri Dish에 DI Water를 정도 담아서 준비함.

- Sample을 HF + DI Water Petri Dish에 띄운 후, Pipette으로 한 방울 씩 Drop 시킴.

- Flim이 어느정도 들뜨면, 멀리서 Pipette으로 용액을 Push 함.

- 완전히 Lift Off 되었다면, OHP Flim으로 CNT Flim을 들어올리기.

- OHP Flim을 다른 Petri Dish로 옮기면서 남아있을 HF를 DI Water에 Clean 시키기.

- 마지막 Petri Dish에서 CNT Flim을 E-Beam Marked Wafer 위에 올리기.

- N2 Gas로 물 빼주기.
- 90°C Hot Plate에서 1 [min]동안 Soft Bake하기.

- Petri Dish에 남은 용액은 Acid 폐용액통에 버리기.
